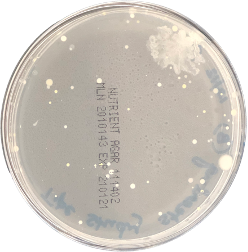
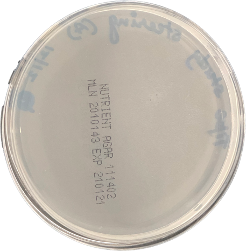
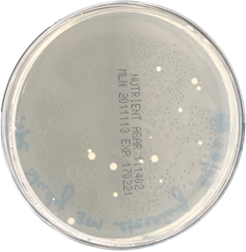

Safety isn’t expensive. It’s priceless
We work hard to make sure our clients can breathe clean indoor air, move freely in sanitized spaces, and have the confidence to touch surfaces without worrying. We are on a mission to create better, safer, and hygienic spaces with nanotechnology & other avant-garde solutions.
How Nano-Coating Solutions Work
Nano-Coating solutions improve surface hygiene by reducing the number of pathogens and harmful organic compounds present in surfaces and in the air. Upon coating, surfaces become resistant to dirt and easier to clean without the need to use harmful chemicals.
Superior in destroying viruses & bacteria
The effect of photocatalytic coatings has been proven by researchers at the University of Tampere, Finland. Photocatalysis destroys 98 % of influenza viruses within 2 hours in regular room light and takes only 30 mins with Blue Light Exposure.
Photocatalytic coating works with light. After the treatment, the photocatalytic coating is activated within a few hours. It keeps working around the clock and only needs light to activate. It can be further enhanced with our Blue Light Technology for optimal results.
A New Dimension of Surface Hygiene - Our Process
Benefits of Photocatalytic Coating
Activated by normal room light, the photocatalytic coating works round the clock, destroying viruses and microbes, thus preventing the spread of infectious diseases.
- Minimizes risks of spreading infectious diseases in high traffic places
- Ensures good surface hygiene against infectious diseases
- Boost your company’s image and persona with safe & clean spaces
- Increase staff productivity by reducing illnesses among your staff
- Eliminate toxic chemicals used in normal cleaning procedures
- Save on cleaning costs
Outstanding Results
(TVC - cfu/ml)
84 cfu/ml - This is before the treatment, i.e., before applying Tipe coating.
(TVC - cfu/ml)
No Growth (100% reduction) - This is after treatment, i.e., after applying Tipe coating and allowing a contact time of atleast 6 hrs.
(TVC - cfu/ml)
17 cfu/ml (80% reduction) - This is after 2 months. This shows that even after two months duration, it still shows excellent reduction results in the microbial growth.
Industries We Serve
Other Applications
CONTACT US
PO Box 6012, Dubai, UAE.









